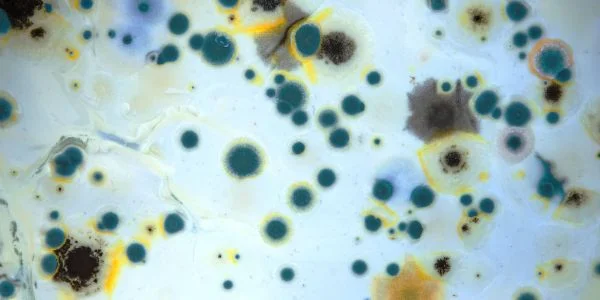
Service 5

Unlock Affordable Mold Fixes Now
For over 15 years, Carolina Duct & Crawl has been the trusted local choice for homeowners across Charlotte, Concord, Huntersville, Matthews, Pineville, Mint Hill, and all of Mecklenburg County. We specialize in complete mold remediation for ducts, crawl spaces, attics, and basements, turning worried families into relieved neighbors with clean, safe air.
We stand by a simple promise: clear, fair pricing that fits your needs, with no smoke and mirrors. In Charlotte, average mold remediation runs $1,100 to $3,800 about $2,400 for most jobs shaped by infestation size or hidden moisture sources. We inspect every nook, quote upfront, and fix the root cause so mold doesn’t sneak back, giving you lasting peace without breaking the bank.
Our pros bring IICRC certification and a no-nonsense process: contain, remove, restore. Costs shift with factors like mold extent small spots stay under
$1,000 while attic overhauls hit
$3,000+ where toxic strains need extra safety gear. We keep it efficient, focusing on your home’s unique setup for results that shine.
Trust us for mold-free living that feels right healthy home, happy family. Book Now for your free quote today!
Book Now